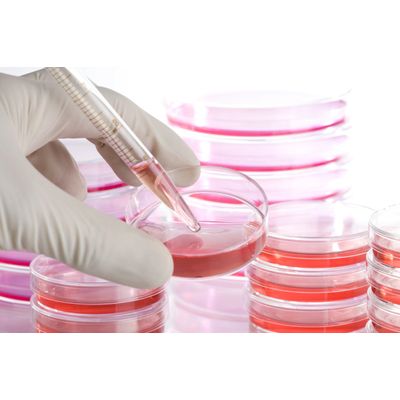

Inovarion
Inovarion - Cellular and Molecular Biology Technology
FromInovarion
Cellular and molecular biology explores the links between cellular functions and associated mechanisms at the molecular level. Thus, the fields of application of molecular biology are numerous:
Most popular related searches
molecular biology
nucleic acid sequencing
nucleic acid
protein analyzer
protein analysis
bioengineering
biochemistry
proteomics
respirator
- Structural and functional biochemistry of nucleic acids, sequencing, replication, transcription, gene regulation, epigenetics
- Purification and characterization of proteins, proteomic analyses, identification of partners of multi-protein complexes, post-translational modifications, study of non-covalent interactions
- Cell signalling and differentiation, cell cycle, proliferation, specification, determination, terminal differentiation, chromatin remodeling, cell-cell interactions, cell-matrix interactions, cell migration, diffusible factors, cytoskeleton
- Cellular metabolism, bioenergetics, anabolism, catabolism, cellular respiration, metabolomics, fluxomics
- Immunology, immunopathologies, immunotherapies, bioengineering, vaccination
- Microbiology, bacteriology, parasitology, mycology, virology
In all these fields, Inovarion’s experts will provide you all the necessary skills to carry out your research projects.
